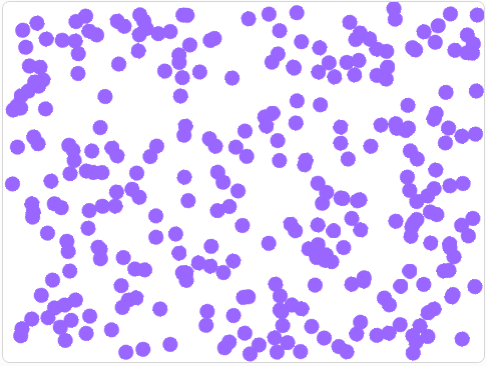
02bd15dc85905c0a84e73b11a536b8a4.png 02bd15dc85905c0a84e73b11a536b8a4.png

02bd15dc85905c0a84e73b11a536b8a4.png
Taille de cette prévisualisation: 486 × 366 pixels. Autres résolutions: 48 × 36 pixels 121 × 91 pixels 243 × 183 pixels 364 × 274 pixels 486 × 366 pixels
scratc:02bd15dc85905c0a84e73b11a536b8a4.png ( 486 × 366 pixels )
Information
| Date : | 2021/11/03 10:35 |
|---|---|
| Nom de fichier : | 02bd15dc85905c0a84e73b11a536b8a4.png |
| Format : | PNG |
| Taille : | 44KB |
| Largeur : | 486 |
| Hauteur : | 366 |
Utilisé sur
En raison des restrictions dans les ACL et de pages cachées, cette liste peut ne pas être complète.
- scratc/animations_en_sciences_physiques.txt
- Dernière modification : 2021/11/03 15:06
- de physix